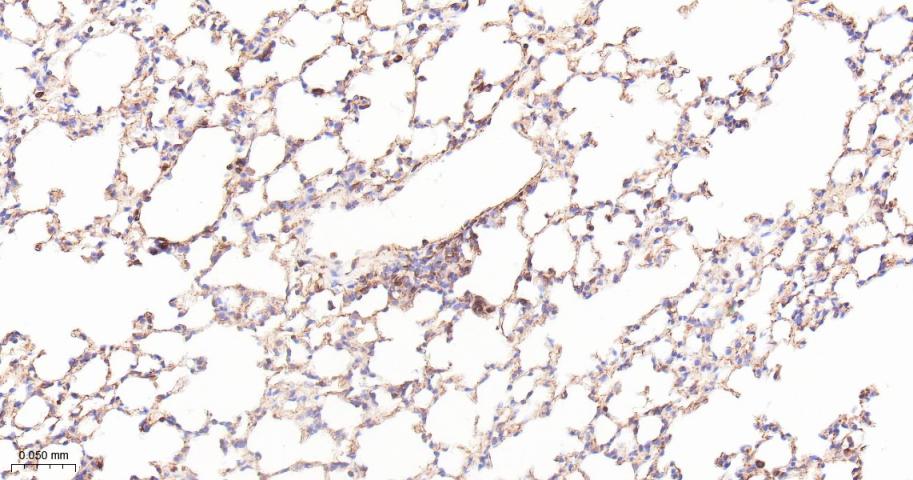
ADAM17重组兔单抗
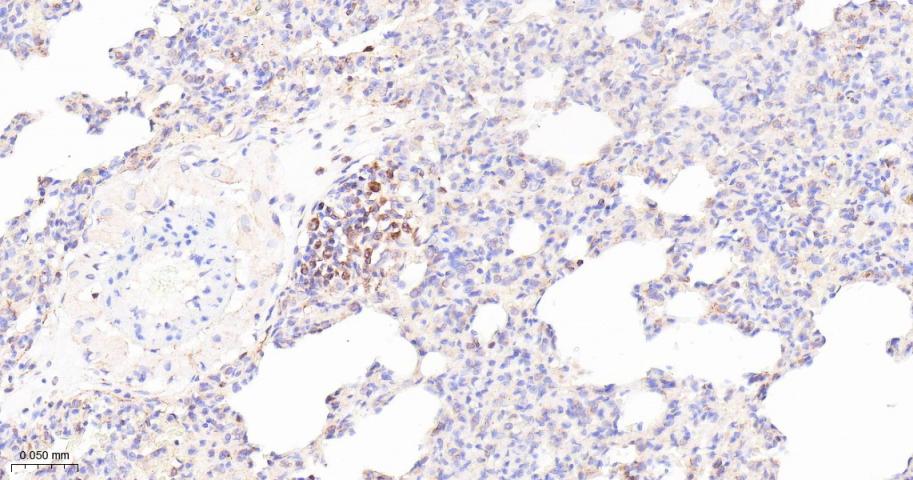
ADAM17重组兔单抗

ADAM17重组兔单抗
Rrmab?兔单抗

货号:bsm-52009R
产品详情
相关标记
相关产品
相关文献
常见问题
概述
产品编号
bsm-52009R
产品类型
重组兔单抗
英文名称
ADAM17 Recombinant Rabbit mAb
中文名称
ADAM17重组兔单抗
英文别名
ADAM18; CD156B; CSVP; NISBD; NISBD1; TACE; ADA17_HUMAN; ADAM17; ADAM 17; Snake venom-like protease; TNF-alpha convertase; TNF-alpha-converting enzyme; 3.4.24.86; ADA17_MOUSE; ADA17_RAT;
抗体来源
Rabbit
免疫原
A synthesized peptide derived from human ADAM 17: 750-784 <Cytoplasmic>
亚型
IgG
性状
Liquid
纯化方法
affinity purified by Protein A
克隆类型
Recombinant
克隆号
9E7
理论分子量
93 kDa
浓度
1mg/ml
储存液
0.01M TBS (pH7.4) with 1% BSA, 0.02% Proclin300 and 50% Glycerol.
研究领域
Cancer > Cancer Metabolism > Response to hypoxia
Cancer > Invasion/microenvironment > ECM > Extracellular matrix > ADAM protein family
Cell Biology > Proteolysis / Ubiquitin > Proteolytic enzymes > Metalloprotease > ADAMs
Metabolism > Pathways and Processes > Metabolism processes > Hypoxia
Metabolism > Types of disease > Cancer
Metabolism > Types of disease > Neurodegenerative disease
Microbiology > Organism > Virus > RNA Virus > ssRNA positive strand virus > SARS Coronavirus
Neuroscience > Neurology process > Neurodegenerative disease > Alzheimer's disease
SWISS
Gene ID
保存条件
Shipped at 4℃. Store at -20℃ for one year. Avoid repeated freeze/thaw cycles.
注意事项
This product as supplied is intended for research use only, not for use in human, therapeutic or diagnostic applications.
数据库链接
背景资料
This gene encodes a member of the ADAM (a disintegrin and metalloprotease domain) family. Members of this family are membrane-anchored proteins structurally related to snake venom disintegrins, and have been implicated in a variety of biologic processes involving cell-cell and cell-matrix interactions, including fertilization, muscle development, and neurogenesis. The protein encoded by this gene functions as a tumor necrosis factor-alpha converting enzyme; binds mitotic arrest deficient 2 protein; and also plays a prominent role in the activation of the Notch signaling pathway. [provided by RefSeq].

产品应用
| 应用 | 已检合格种属 | 预测种属 | 推荐稀释比例 |
|---|---|---|---|
| WB | Human | Mouse, Rat | 1:500-2000 |
| IHC-P | Human, Mouse, Rat | 1:100-500 | |
| IHC-F | Human, Mouse, Rat | 1:100-500 | |
| IF | Human, Mouse, Rat | 1:100-500 | |
| Flow-Cyt | Human, Mouse, Rat | 1:50-100 | |
| ICC/IF | Human | Mouse, Rat | 1:50-200 |
交叉反应
交叉反应: Human, Mouse, Rat
相关产品
暂无相关产品
靶标
基因名
ADAM17
蛋白名
Disintegrin and metalloproteinase domain-containing protein 17
亚基
Interacts with MAD2L1, MAPK14 and MUC1.
亚细胞定位
Membrane.
组织特异性
Ubiquitously expressed. Expressed at highest levels in adult heart, placenta, skeletal muscle, pancreas, spleen, thymus, prostate, testes, ovary and small intestine, and in fetal brain, lung, liver and kidney.
相似性
Contains 1 disintegrin domain.
Contains 1 peptidase M12B domain.
Contains 1 peptidase M12B domain.
功能
Cleaves the membrane-bound precursor of TNF-alpha to its mature soluble form. Responsible for the proteolytical release of soluble JAM3 from endothelial cells surface. Responsible for the proteolytic release of several other cell-surface proteins, including p75 TNF-receptor, interleukin 1 receptor type II, p55 TNF-receptor, transforming growth factor-alpha, L-selectin, growth hormone receptor, MUC1 and the amyloid precursor protein. Also involved in the activation of Notch pathway (By similarity).
标记抗体
暂无标记数据
同靶标产品
暂无同靶标产品
相关文献
提示: 发表研究结果有使用 bsm-52009R 时请让我们知道,以便我们可以引用参考文章。作为回馈,资料提供者将获得我们送上的小礼品。
暂无相关文献
常见问题
暂无常见问题